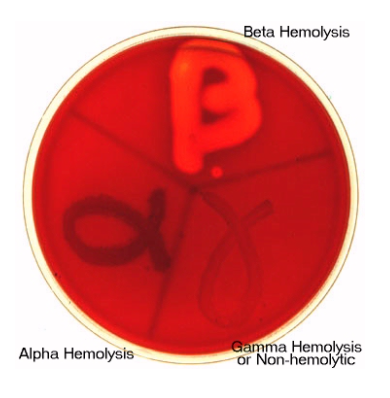

kjsdgzhfdk
qkjhkjasf
What Staph aureus virulence factor binds to prothrombin and creates staphylothrombin, in order to form clots?
Coagulase
What Gram POS virulence factor forms holes in red blood cells?
Hemolysin
Why are patients with renal disease susceptible to pneumonias?
Chronic uremia damages lungs, increases infection risk.
Main causative bacteria in acute shellfish poisoning
Vibrio (V. vulnificus or V. parahaemolyticus)
Strep. pyogenes adhesion protein
Protein F
Staph aurus anti-adhesion protein
Protein A
Lipoteichoic acid (LTA): Gram POS or Gram NEG?
Gram POS
Lipopolysaccharide (LPS): Gram POS or Gram NEG?
Gram NEG
What does the Strep. pyogenes adhesion factor, protein F bind to?
Fibronectin
What does the Staph. aureus anti-adhesion factor, protein A bind to?
Immunoglobulins (IgG Fc region)
What clot-digesting enzyme does streptokinase (from Strep. pyogenes) activate?
Plasminogen (to form active plasmin)
What clot-digesting enzyme does staphylokinase (from Staph. aureus) activate?
Plasminogen (to active plasmin)
Why can treatment with the thrombolytic drug streptokinase cause hypotension?
It converts kininogen to bradykinin, which is a vasodilator
What tissue-digesting enzyme does Clostridium hystolyticum make?
Collagenase
Name an indication for use of Clostridium histolyticum collagenase (as an injectible drug).
Dupuytren’s contracture
What bacteria secretes alpha hemolysin (which lyses RBCs)?
Staph. aureus
What reaction does catalase perform?
2H2O2 –> 2H2O + O2 (gets rid of hydrogen peroxide)
What type of hemolysis: Strep. pneumoniae?
Alpha (incomplete)

What type of hemolysis: Viridans groups Strep. (e.g. Strep. mutans)?
Alpha (incomplete)

What type of hemolysis: Staph. aureus?
Beta (complete)
What type of hemolysis: Strep. pyogenes?
Beta (complete)

What type of hemolysis: Strep. agalactiae (Group B Strep)?
Beta (complete)
